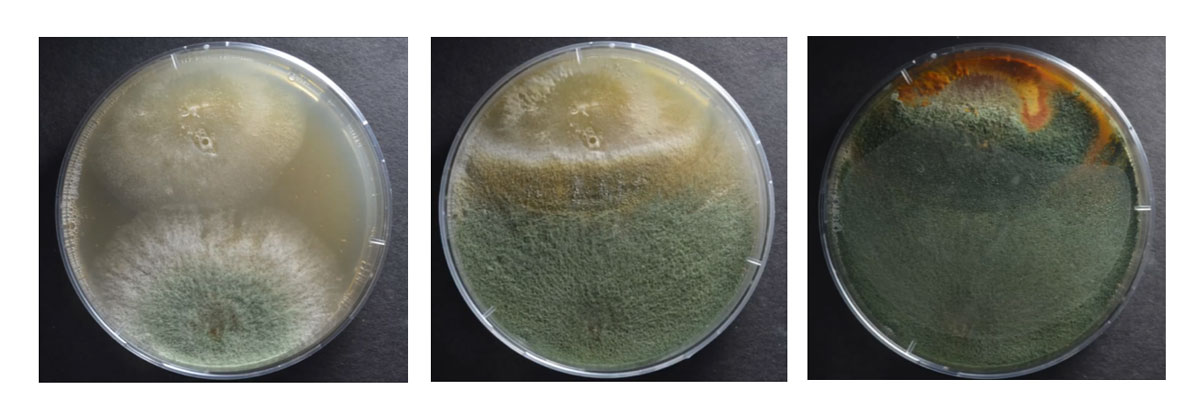

Introduzione ai microrganismi utili in agricoltura
a cura di Alessio Capezzuoli
Un’introduzione pratica e teorica al mondo invisibile che vive sotto i nostri piedi. Esploreremo i processi di pedogenesi con un focus particolare sul ruolo dei microrganismi nel formare e trasformare il suolo.
Durante il laboratorio impareremo ad autoprodurci microrganismi. La tecnica consiste nell’estrazione della microflora utile tramite lavaggio del lombricompost che abbiamo precedentemente preparato. Questo processo permette di trasferire batteri e altri microrganismi benefici dal compost al liquido, senza processi di fermentazione, mantenendo una soluzione stabile e facilmente applicabile.
Il preparato ottenuto può essere distribuito su suolo e colture per stimolare l’attività biologica e migliorare la fertilità in modo semplice ed economico.
Attività a numero chiuso, iscrizione obbligatoria.
Per iscrizioni clicca sul pulsante “REGISTRATI ORA“ ☜